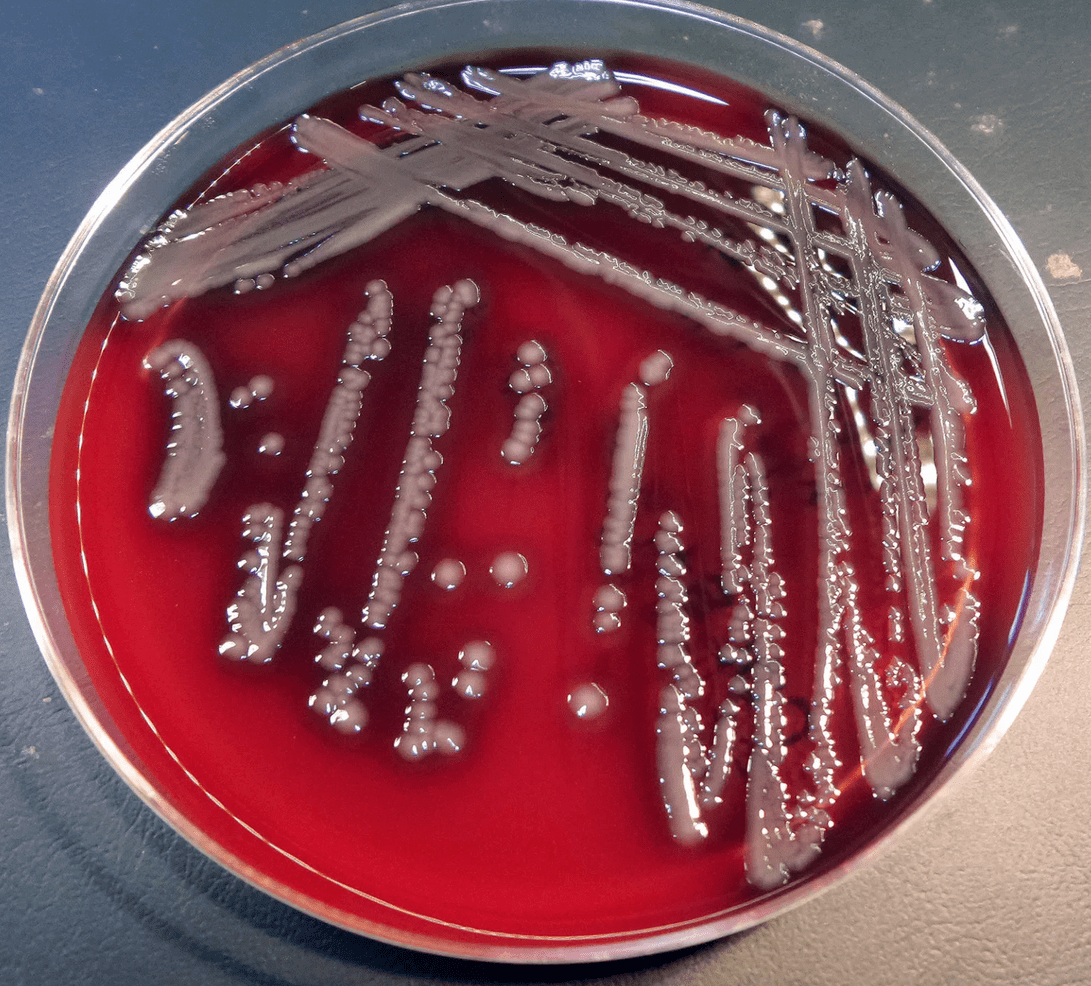

Содержание статьи:
- Биоценоз
- Аэромонас и Азомонас
- Положительную роль растений в жизни рыб трудно переоценить
- Если вести речь о простейших червях и насекомых, то отношения с рыбами у них неоднозначные
- Важную роль в жизни подводных обитателей играют и моллюски
- Про мелких ракообразных (дафниях, циклопах) можно сказать практически тоже самое
В озерах, водохранилищах, реках да по берегам водоемов рядом с рыбой мирно и не очень сосуществует множество живых существ, и все это общежитие наука называет биоценозом. Наверное и мы, рыболовы, днюющие и ночующие на своей любимой рыбалке, также в какой-то степени причастны к этому самому биоценозу – ну и отлично, чем больше узнаем о жизни любимых водоемов, тем большее удовольствие получим от рыбалки.

Биоценоз
Рыбы связаны с окружающим миром с помощью тысяч невидимых, но очень прочных нитей. А в воде, кроме рыб, живет великое множество существ разного уровня организации – от бактерий и вирусов до млекопитающих. И все они – лягушки, жуки, раки, прудовики, пиявки, бобры – связаны между собой и рыбой.
Целая сложная сеть получается, имя которой – биоценоз. Кто-то из соседей по биоценозу причиняет рыбе несомненный вред, кто-то приносит пользу (хотя отношения с пищевыми объектами назвать дружбой проблематично). Взять, к примеру, бактерии и вирусы.
Конечно, бактерии и вирусы у рыб часто вызывают страшные смертельные заболевания – эпизоотии. Но большинство бактерий, обитающих в воде, мирно разлагают органику или занимаются хемосинтезом, не помышляя ни о чем плохом.
А есть среди них и маленькие друзья рыб. Вот, к примеру, взять двух непохожих, но обладающих созвучными именами бактерий – Аэромонас и Азомонас. Обе они – постоянные обитатели рыбоводных прудов и естественных водоемов. Но на этом их сходство заканчивается.
Аэромонас и Азомонас
Аэромонас, мелкая чахлая палочка, вызывает у рыб страшное заболевание – аэромоноз, или, как его ранее называли, «краснуху». При этом рыба становится красной, раздутой, пучеглазой, тело покрывается язвами. Заболевшая особь может выздороветь, но может и погибнуть. Если не лечить болезнь, то второй исход более вероятен.
А вот Азомонасы, крупные, массивные клетки, никогда не позволяют себе паразитировать на живом организме. Они обладают способностью связывать свободный азот, превращать его в доступные всему живому формы, за что им большая благодарность от всей экосистемы водоема. Кроме того, они терпеть не могут мелких вредных бактерий и вытесняют их отовсюду, где появляются сами.
Положительную роль растений в жизни рыб трудно переоценить
Это и убежище (многие виды в процессе эволюции приобрели специальную покровительственную окраску, помогающую быть незаметной в траве), и субстрат для откладывания икры, и пища (толстолобик, белый амур, красноперка, подуст питаются водорослями).
Но самое главное – зеленые растения являются поставщиками кислорода и создателями органики из неорганических веществ. Они – начало любой пищевой цепочки, основа жизни, базис, без них невозможна жизнь не только в водоеме, но и на нашей планете в целом.
Если вести речь о простейших червях и насекомых, то отношения с рыбами у них неоднозначные
Да, кольчатые и малощетинковые черви являются излюбленной пищей для многих подводных обителей. Питательные, высокобелковые, совершенно безобидные – лакомство для рыбы. Но встречаются среди червей и паразиты, досаждающие рыбам не менее чем бактерии и вирусы.
Например, лигулы поселяются в брюшной полости, цестоды разных видов – в кишечнике, филометра – под чешуей, диплостомы – в глазах. Зараженная особь пухнет, слепнет, покрывается язвами и гибнет.
Многих личинок насекомых рыба с удовольствием поедает. Это еда для нее не хуже, чем пресловутые черви. Но личинки жуков – плавунцов и стрекоз можно смело назвать опасными вредителями. Они поедают икру, нападают на мальков. Взрослые жуки – плавунцы могут существенно проредить карповую молодь в искусственном пруду, если им дать волю.
Привлеченные запахом крови эти насекомые могут напасть даже на взрослую подраненную рыбу – самые настоящие враги рыбы! А ведь еще есть отвратительные гладыши, водяные скорпионы, которые также не упустят возможности напасть на беззащитных мальков.
Важную роль в жизни подводных обитателей играют и моллюски
Формы взаимосвязи рыб и моллюсков довольно разнообразны. На первом плане, конечно, отношения «корм-потребитель». Корм, естественно, моллюски, потребитель – рыба. Моллюсков любят почти все рыбы (кроме растительноядных видов – амура и толстолобика), мясо-то у них вкусное, питательное.
В какой-то степени их защищает раковина, но для крупных особей, например, карпа, леща, язя, сига, и она не помеха. В мантийную полость ракушки беззубки горчаки откладывают икру, там же выводятся их мальки, и туда же, в ракушку к «приемной маме», долго еще шныряют они при малейшей опасности.
В общем, моллюски – сами по себе достаточно безобидные и даже беззащитные существа. Но они же, в силу своей мягкотелости и беззащитности, часто становятся мишенью для многих паразитов, поражающих рыб. Нередко они являются разносчиками и промежуточными хозяевами возбудителей опасных заболеваний рыб, например, паразитарной катаракты (диплостомоза) и сангвилликолеза.
Впрочем, сами «ракушки» тоже, бывает, ведут себя нагло: на рыбах паразитируют глохидии (личинки) перловиц и беззубок. Причем личинки (как и родители), дотрагиваясь до тела рыбы, быстро захлопывают створки, повисая на самых мягких и чувствительных местах – жабрах и плавниках. Но стоит заметить, что большого вреда они рыбе не наносят.
Про мелких ракообразных (дафниях, циклопах) можно сказать практически тоже самое
Планктоном (от греческого слова planktos – парящий) питаются почти все виды рыб в начале своей жизни, а некоторые – всю сознательную жизнь. Самое интересное, что яйца мелких рачков, которые самки «высиживают» в специальных сумках, не перевариваются в кишечнике рыб!

Рыба съедает почти весь планктон за сезон, а на следующий сезон его еще больше! Правда, случаются и казусы: крупные циклопы могут нападать на только что выклюнувшихся личинок рыб. Но происходит подобное только в те годы, когда нерест рыбы и развитие икры по каким-то причинам сильно запаздывает.
Такое происходит довольно редко, данную систему отношений природа разрешила все-таки в пользу рыб: массовое развитие циклопов в нормальных условиях происходит тогда, когда ими уже могут питаться мальки, а не наоборот.
Кроме того, рачки покрупнее (аргулюсы, эргазилюсы, синергазилюсы) могут паразитировать на рыбах: вцепятся в жабры, плавники и в бока, и катаются, высасывая из тела питательные соки. Один-два рачка еще не беда, а вот если их несколько сотен на жабрах — это уже опасное явление.